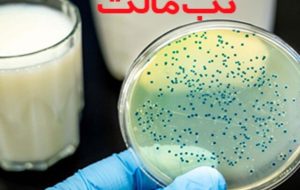
ابتلا به تب مالت در کرمانشاه ۳۴ درصد کاهش یافت

فریبرز ایمانی در گفتگو با خبرنگار مهر، از کاهش قابل توجه موارد ابتلا به تب مالت در استان کرمانشاه خبر داد و اظهار کرد: این دستاورد حاصل همکاری مؤثر بخشهای بهداشتی و دامپزشکی است.
وی با اشاره به آمار ابتلا افزود: در سال ۱۴۰۳ تعداد ۵۹۸ مورد ابتلا به ثبت رسیده بود که این رقم در سال ۱۴۰۴ به ۳۹۳ مورد کاهش یافته و نشاندهنده افت ۳۴ درصدی است.
معاون بهداشتی دانشگاه علوم پزشکی کرمانشاه ادامه داد: اجرای دقیق برنامههای واکسیناسیون دام و نظارت بر روند تولید و عرضه محصولات دامی، نقش مهمی در کنترل این بیماری داشته است.
وی همچنین افزایش آگاهی عمومی را یکی از عوامل مؤثر دانست و گفت: توجه مردم به مصرف لبنیات پاستوریزه و رعایت نکات بهداشتی، در کاهش موارد ابتلا تأثیرگذار بوده است.
ایمانی در پایان با تأکید بر ضرورت تداوم این روند افزود: همکاری مردم و دامداران در رعایت اصول بهداشتی میتواند به استمرار کاهش موارد ابتلا در سالهای آینده کمک کند.

ارسال نظر شما
مجموع نظرات : 0 در انتظار بررسی : 0 انتشار یافته : 0